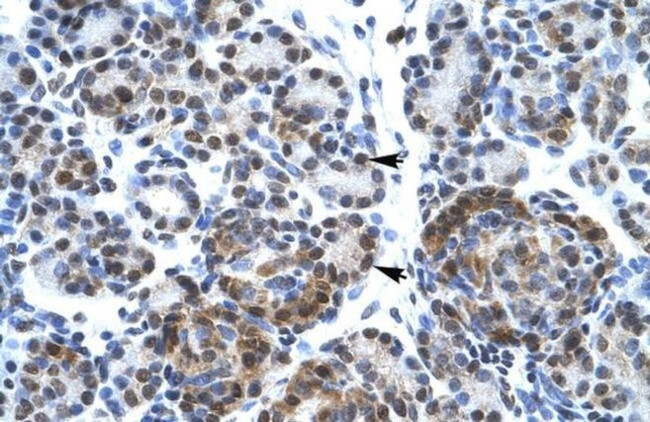
SPT5 Antibody in Immunohistochemistry (Paraffin) (IHC (P))

Search
Invitrogen
SPT5 Polyclonal Antibody
{{$productOrderCtrl.translations['antibody.pdp.commerceCard.promotion.promotions']}}
{{$productOrderCtrl.translations['antibody.pdp.commerceCard.promotion.viewpromo']}}
{{$productOrderCtrl.translations['antibody.pdp.commerceCard.promotion.promocode']}}: {{promo.promoCode}} {{promo.promoTitle}} {{promo.promoDescription}}. {{$productOrderCtrl.translations['antibody.pdp.commerceCard.promotion.learnmore']}}







Please note: We are reviewing Western blot images included in the antibody testing data in our catalog, including those provided by third parties. Unless expressly labeled or annotated as “raw-unedited”, Western blot images included in the antibody testing data in our catalog may have been edited, optimized or otherwise adjusted for presentation.
产品信息
PA5-40709
种属反应
宿主/亚型
分类
类型
抗原
偶联物
形式
浓度
规格
纯化类型
保存液
内含物
保存条件
运输条件
RRID
产品详细信息
Peptide sequence: PYAAPSPQGS YQPSPSPQSY HQVAPSPAGY QNTHSPASYH PTPSPMAYQA
Sequence homology: Cow: 100%; Dog: 100%; Guinea Pig: 100%; Horse: 100%; Human: 100%; Rabbit: 100%; Zebrafish: 92%
靶标信息
Component of the DRB sensitivity-inducing factor complex (DSIF complex), which regulates mRNA processing and transcription elongation by RNA polymerase II. DSIF positively regulates mRNA capping by stimulating the mRNA guanylyltransferase activity of RNGTT/CAP1A. DSIF also acts cooperatively with the negative elongation factor complex (NELF complex) to enhance transcriptional pausing at sites proximal to the promoter. Transcriptional pausing may facilitate the assembly of an elongation competent RNA polymerase II complex. DSIF and NELF promote pausing by inhibition of the transcription elongation factor TFIIS/S-II. TFIIS/S-II binds to RNA polymerase II at transcription pause sites and stimulates the weak intrinsic nuclease activity of the enzyme. Cleavage of blocked transcripts by RNA polymerase II promotes the resumption of transcription from the new 3' terminus and may allow repeated attempts at transcription through natural pause sites. DSIF can also positively regulate transcriptional elongation and is required for the efficient activation of transcriptional elongation by the HIV-1 nuclear transcriptional activator, Tat. DSIF acts to suppress transcriptional pausing in transcripts derived from the HIV-1 LTR and blocks premature release of HIV-1 transcripts at terminator sequences. [UniProt]
仅用于科研。不用于诊断过程。未经明确授权不得转售。
篇参考文献 (0)
生物信息学
蛋白别名: DRB sensitivity-inducing factor 160 kDa subunit; DRB sensitivity-inducing factor large subunit; DSIF large subunit; DSIF p160; hSPT5; suppressor of Ty 5 homolog; Tat-cotransactivator 1 protein; Tat-CT1 protein; Transcription elongation factor SPT5; unnamed protein product
基因别名: SPT5; SPT5H; SUPT5H; Tat-CT1
Entrez Gene ID: (Human) 6829